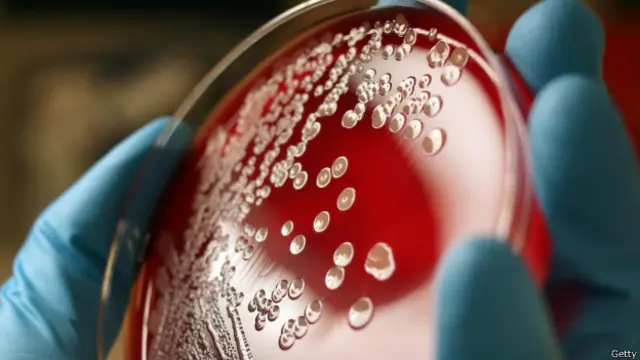
नाख़ून

आपके नाख़ूनों में कीटाणु तो नहीं?

इमेज स्रोत, Getty
बीमारियों से बचने के लिए सबसे बड़ा नुस्ख़ा जो बताया जाता है वो है हाथ साफ़ रखने का. डॉक्टर हों या घर के बड़े बुजुर्ग, सब कहते हैं कि अपने हाथ हमेशा साफ़ रखें. शौच के बाद हाथों को साबुन से धोएं. खाने से पहले हाथ ज़रूर धोएं, वग़ैरह. लोग कहते हैं कि हाथ साफ़ रखने से कीटाणु नहीं फैलते. खाने-पीने का धंधा करने वालों को ख़ास तौर से हाथ साफ़ रखने को कहा जाता है.
मगर होता यूं है कि चाहे आप जितना हाथ रगड़ लें, उनसे बैक्टीरिया कभी पूरी तरह ख़त्म नहीं होते. इसीलिए अब मरीज़ों से बात करते वक़्त या उनकी पड़ताल करते वक़्त डॉक्टर और नर्स हाथों में दस्ताने पहनते हैं.
आज से क़रीब सौ साल पहले डॉक्टरों ने देखा कि बार-बार हाथ धोने के बावजूद, हाथों के कीटाणु कभी पूरी तरह ख़त्म नहीं होते. लेकिन, इसकी वजह पता चलने में दो तिहाई सदी गुज़र गई.
सत्तर के दशक में जाकर इसकी वजह सामने आई. पता ये चला कि अगर आप अपनी उंगलियों के पोरों को साफ़ रखते हैं तो कीटाणु कम फैलते हैं. वैज्ञानिकों की पड़ताल से पता ये चला कि हमारे नाखूनों के नीचे की जो जगह है, वो असल में कीटाणुओं का चिड़ियाघर है.

इमेज स्रोत, Getty
नाखूनों और उंगली के बीच की इस जगह की ठीक से सफ़ाई नहीं हो पाती. साथ ही, हाथ धोने पर यहां का पानी काफ़ी देर तक ठीक से सूखता नहीं. ऐसे माहौल में बैक्टीरिया ख़ूब फलते-फूलते हैं.
1988 में अमरीका की पेन्सिल्वेनिया यूनिवर्सिटी में एक रिसर्च हुआ. जिसमें 26 वॉलंटियर्स और सभी कर्मचारियों के हाथ के नमूने लिए गए. इनमें पाया गया कि नाखूनों और उंगली के बीच की जो जगह है, वहां पर हाथ के बाक़ी हिस्से से ज़्यादा बैक्टीरिया मिले. जहां पूरे हाथ में हज़ारों बैक्टीरिया थे.
वहीं हर एक उंगली के पोर के नीचे लाखों कीटाणु मज़े में रह रहे थे. हाथ धोते वक़्त वहां साबुन मुश्किल से पहुंचता है. उस हिस्से की रगड़कर सफ़ाई भी नहीं होती. यही वजह है कि बैक्टीरिया वहां आराम से फलते-फूलते रहते हैं.
इसमें हमारे लंबे नाखूनों और बनावटी नाखूनों का भी बड़ा योगदान है. 1989 में अमरीका की ही कुछ नर्सों ने बनावटी नाखूनों से मरीज़ों को होने वाले नुक़सान के बारे में लिखा था.
इसके बाद एक रिसर्च हुई. जिसमें 56 बनावटी नाख़ून लगाने वाली नर्सों और 56 क़ुदरती लंबे नाख़ून रखने वाली नर्सों के हाथ के नमूने लिए गए. पाया ये गया कि बनावटी नाख़ूनों के नीचे ज़्यादा बैक्टीरिया पनप रहे थे. वजह ये कि बनावटी नाख़ूनों वाले हाथों की सफ़ाई और भी ठीक से नहीं हो पाती है.
इमेज स्रोत, Getty
साथ ही बनावटी नाख़ूनों वाली नर्सें अपने कीटाणु, मरीज़ों तक भी पहुंचा रही थीं. इसी तरह के तजुर्बे साल 2000 और 2002 में भी सामने आए जिसमें बनावटी नाख़ूनों से होने वाले नुक़सान के बारे में आगाह किया गया.
उनके मुक़ाबले क़ुदरती नाख़ून जिन्हें नेल पेंट से रंगा गया हो, उनके नीचे कम बैक्टीरिया फलते-फूलते हैं. लेकिन रंगे हुए नाख़ूनों के पेंट में पड़ी दरारें भी बैक्टीरिया का ठिकाना बन सकती हैं. 1993 में अमरीका के बाल्टीमोर के जॉन हॉपकिंस इंस्टीट्यूट में हुए एक रिसर्च से ये बात खुलकर सामने आई थी.
इन सब तजुर्बों से एक बात साफ़ है. नाख़ूनों को छोटे रखना और साफ़ रखना बहुत ज़रूरी है. इससे हाथों के कीटाणुओं का पूरी तरह सफ़ाया भले न हो, उनकी तादाद काफ़ी कम हो जाएगी. ताज़ा रंगे हुए नाख़ूनों के नीचे कम बैक्टीरिया होते हैं. मगर चार दिन या इससे ज़्यादा पहले के रंगे नाख़ूनों के नीचे कीटाणुओं की तादाद काफ़ी बढ़ जाती है.
हर साल, दुनिया भर में क़रीब तीस लाख लोग दस्त से मर जाते हैं. जानकार कहते हैं कि अगर हाथों की सलीक़े से सफ़ाई रखी जाए, तो इनमें से दस लाख लोगों की जान बचायी जा सकती है. और अगर हम अपने नाख़ून छोटे रखें, उन्हें साफ़ रखें तो और जानें भी बचायी जा सकती हैं.
तो, ये सब बातें जानकर आप अब तो नाख़ून कुतरना बंद कर देंगे ना!
(अंग्रेजी में मूल लेख के लिए <link type="page"><caption> यहां पढ़ें</caption><url href="http://www.bbc.com/future/story/20160622-what-lives-under-your-fingernails" platform="highweb"/></link>, जो <link type="page"><caption> बीबीसी फ्यूचर</caption><url href="http://www.bbc.com/future" platform="highweb"/></link> पर उपलब्ध है.)
(बीबीसी हिन्दी के एंड्रॉएड ऐप के लिए आप यहां <link type="page"><caption> क्लिक </caption><url href="https://play.google.com/store/apps/details?id=uk.co.bbc.hindi" platform="highweb"/></link>कर सकते हैं. आप हमें <link type="page"><caption> फ़ेसबुक</caption><url href="https://www.facebook.com/bbchindi" platform="highweb"/></link> और <link type="page"><caption> ट्विटर</caption><url href="https://twitter.com/BBCHindi" platform="highweb"/></link> पर फ़ॉलो भी कर सकते हैं.)












